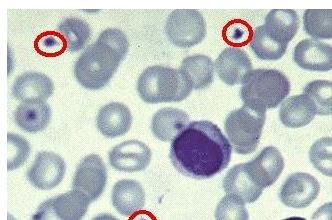

血小板增高有什么危害呢?
快速问专家,今日还剩下16个专家号
免费拨打
免费咨询
血小板在人体中起着很大的作用,所以说如果血小板增高了,或者减少了,对人体的伤害是很多的,此时只有及时了解到血小板增多症有什么危害,我们才能更好的预防和治疗。那么有什么危害呢?请看以下医生介绍。
1、医生表示血小板增高起病缓慢,轻重不同。轻者仅有头昏、乏力,重者可有出血及血栓形成。出血常为自发性,可反反复作,约见于2/3的病倒,以胃肠道出血常见,也可有、齿龈出血、血尿、皮 肤粘膜瘀斑,但紫癜少见。
2、血小板增高会造成患者血管栓塞,可表现肢体麻木、疼痛,甚至坏疽,也有表现红斑性肢痛病。肺、脑、肾栓塞引起相应临床症状;中国统计脾肿大约占80%,一般为中度。少数病人有肝肿大。
3、血小板增高患者还会红斑性肢痛病。脾及肠系膜血 管栓塞可致腹痛、呕吐。肺、脑、肾栓塞引起相应临床症状。晚期原发性血小板增多症,可有肝脏和其他脏器的髓外严重出血。
如果患了血小板增高如何***呢?济南血液病医院推出的“中西医结合治疗”是治疗血小板增高的很好方法,值得患者考虑。
温馨提示:以上介绍希望对大家有帮助,中西医结合“中西医结合”对患者的康复治疗起到关键的作用。如果还有什么不明白的地方,可以拨打全国咨询电话:0531-8695 3333 可与医生在线交流。
相关阅读
上一篇:血小板增多的危害?
下一篇:血小板高的危害是什么?
你是不是还想了解以下问题
- 能治好吗
- 反复发作怎么办
- 需要多少钱
- 什么方法有效
- 多久能治好
- 哪家医院效果好

-
 无假日医院
无假日医院 -
 一对一服务
一对一服务 -
 24小时在线
24小时在线 -
 预约免排队
预约免排队
- 在线咨询
- 预约挂号
- 来院路线
- 返回顶部
济南血液病医院
咨询热线:0531-8695 3333
备案号:鲁ICP备12006985号
工信部链接:http://beian.miit.gov.cn